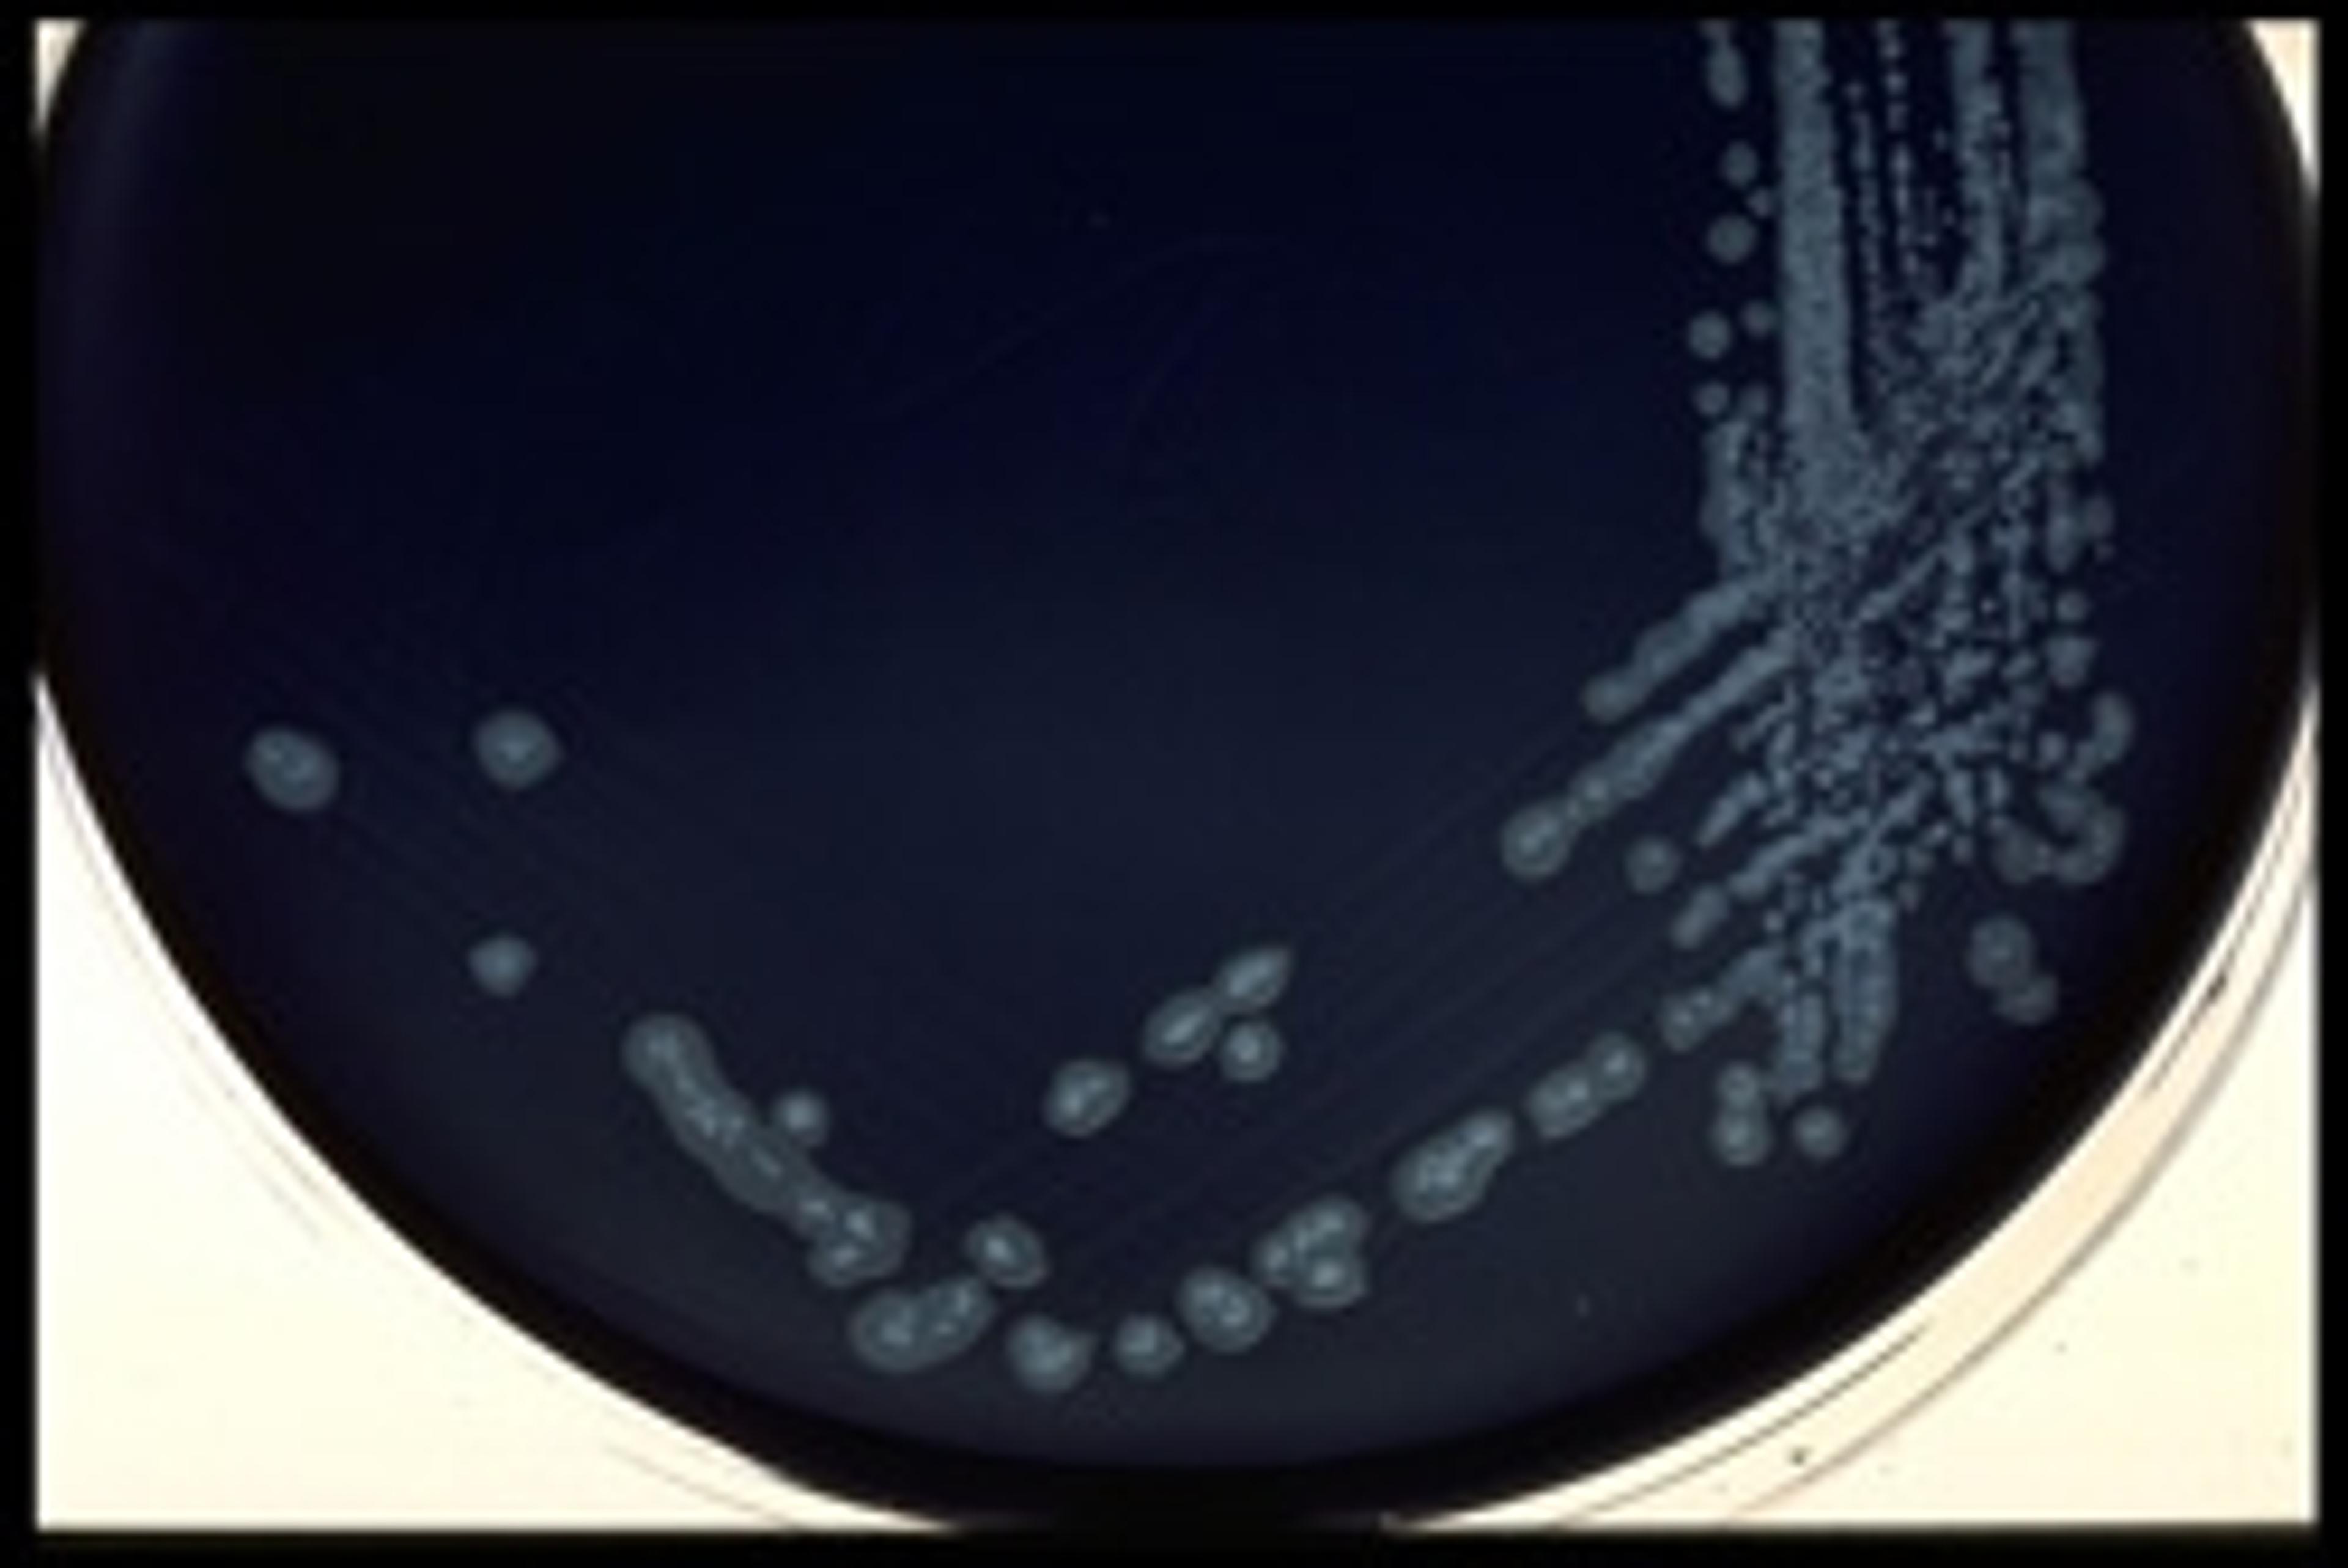
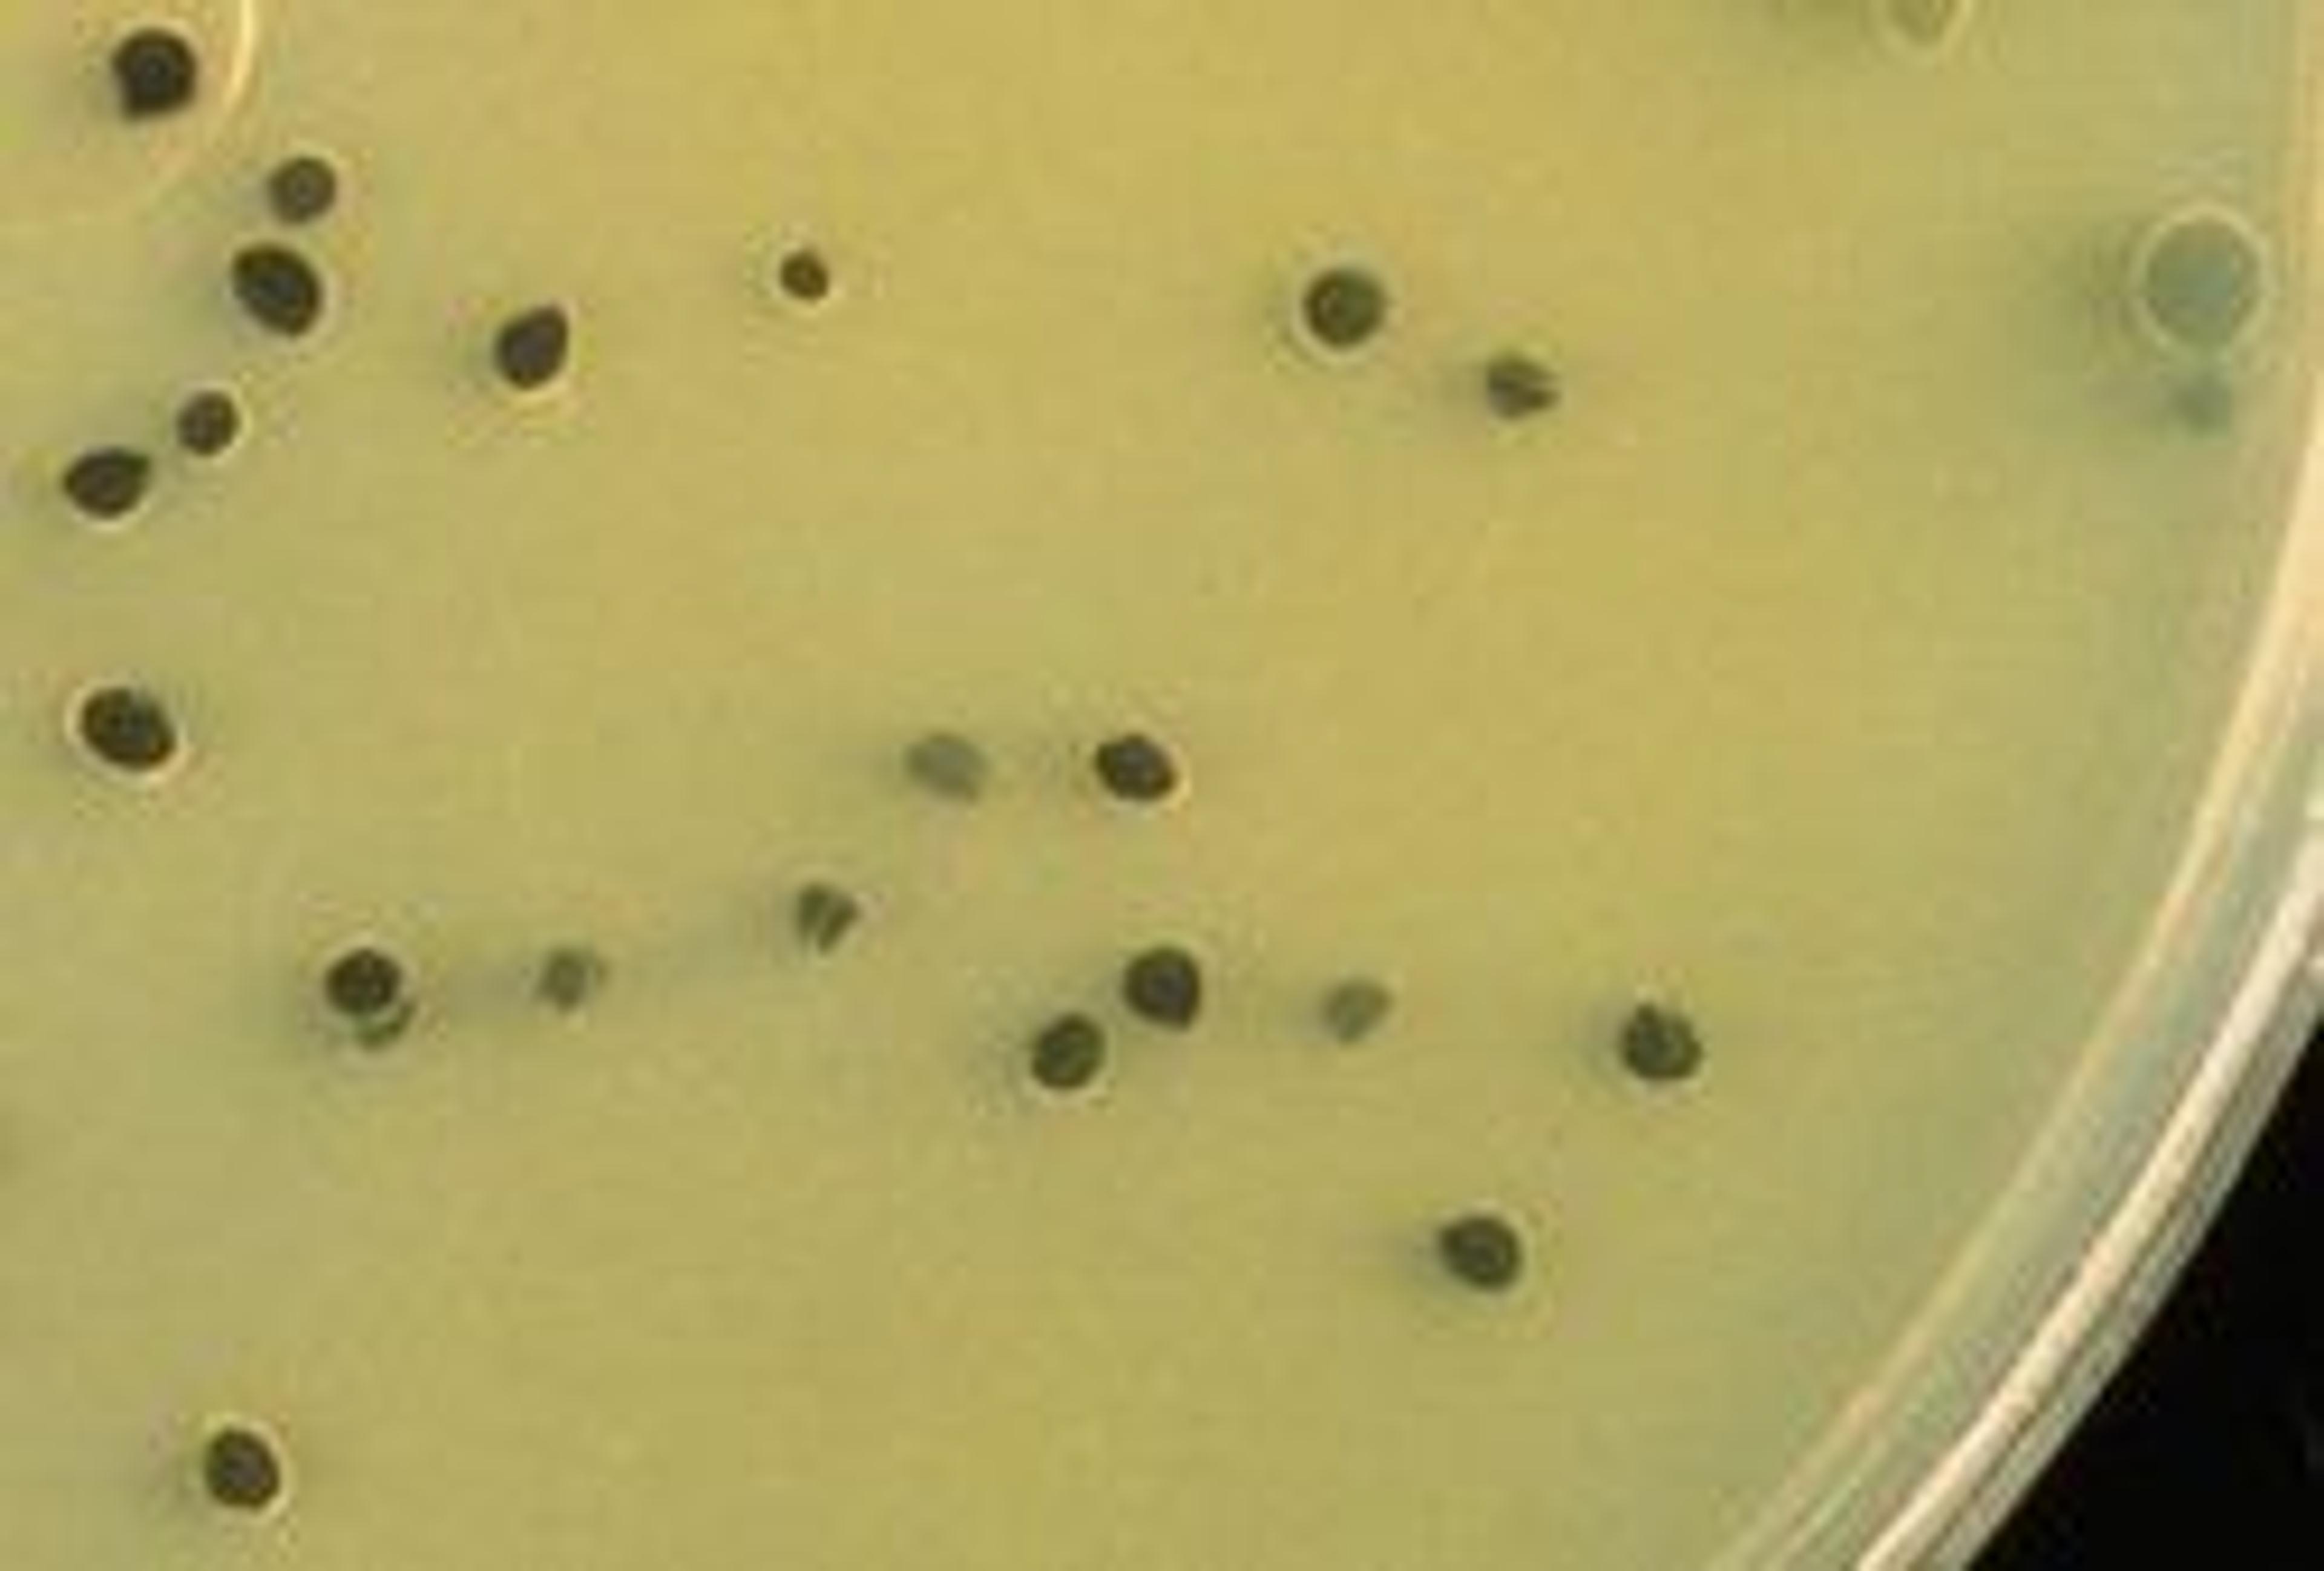
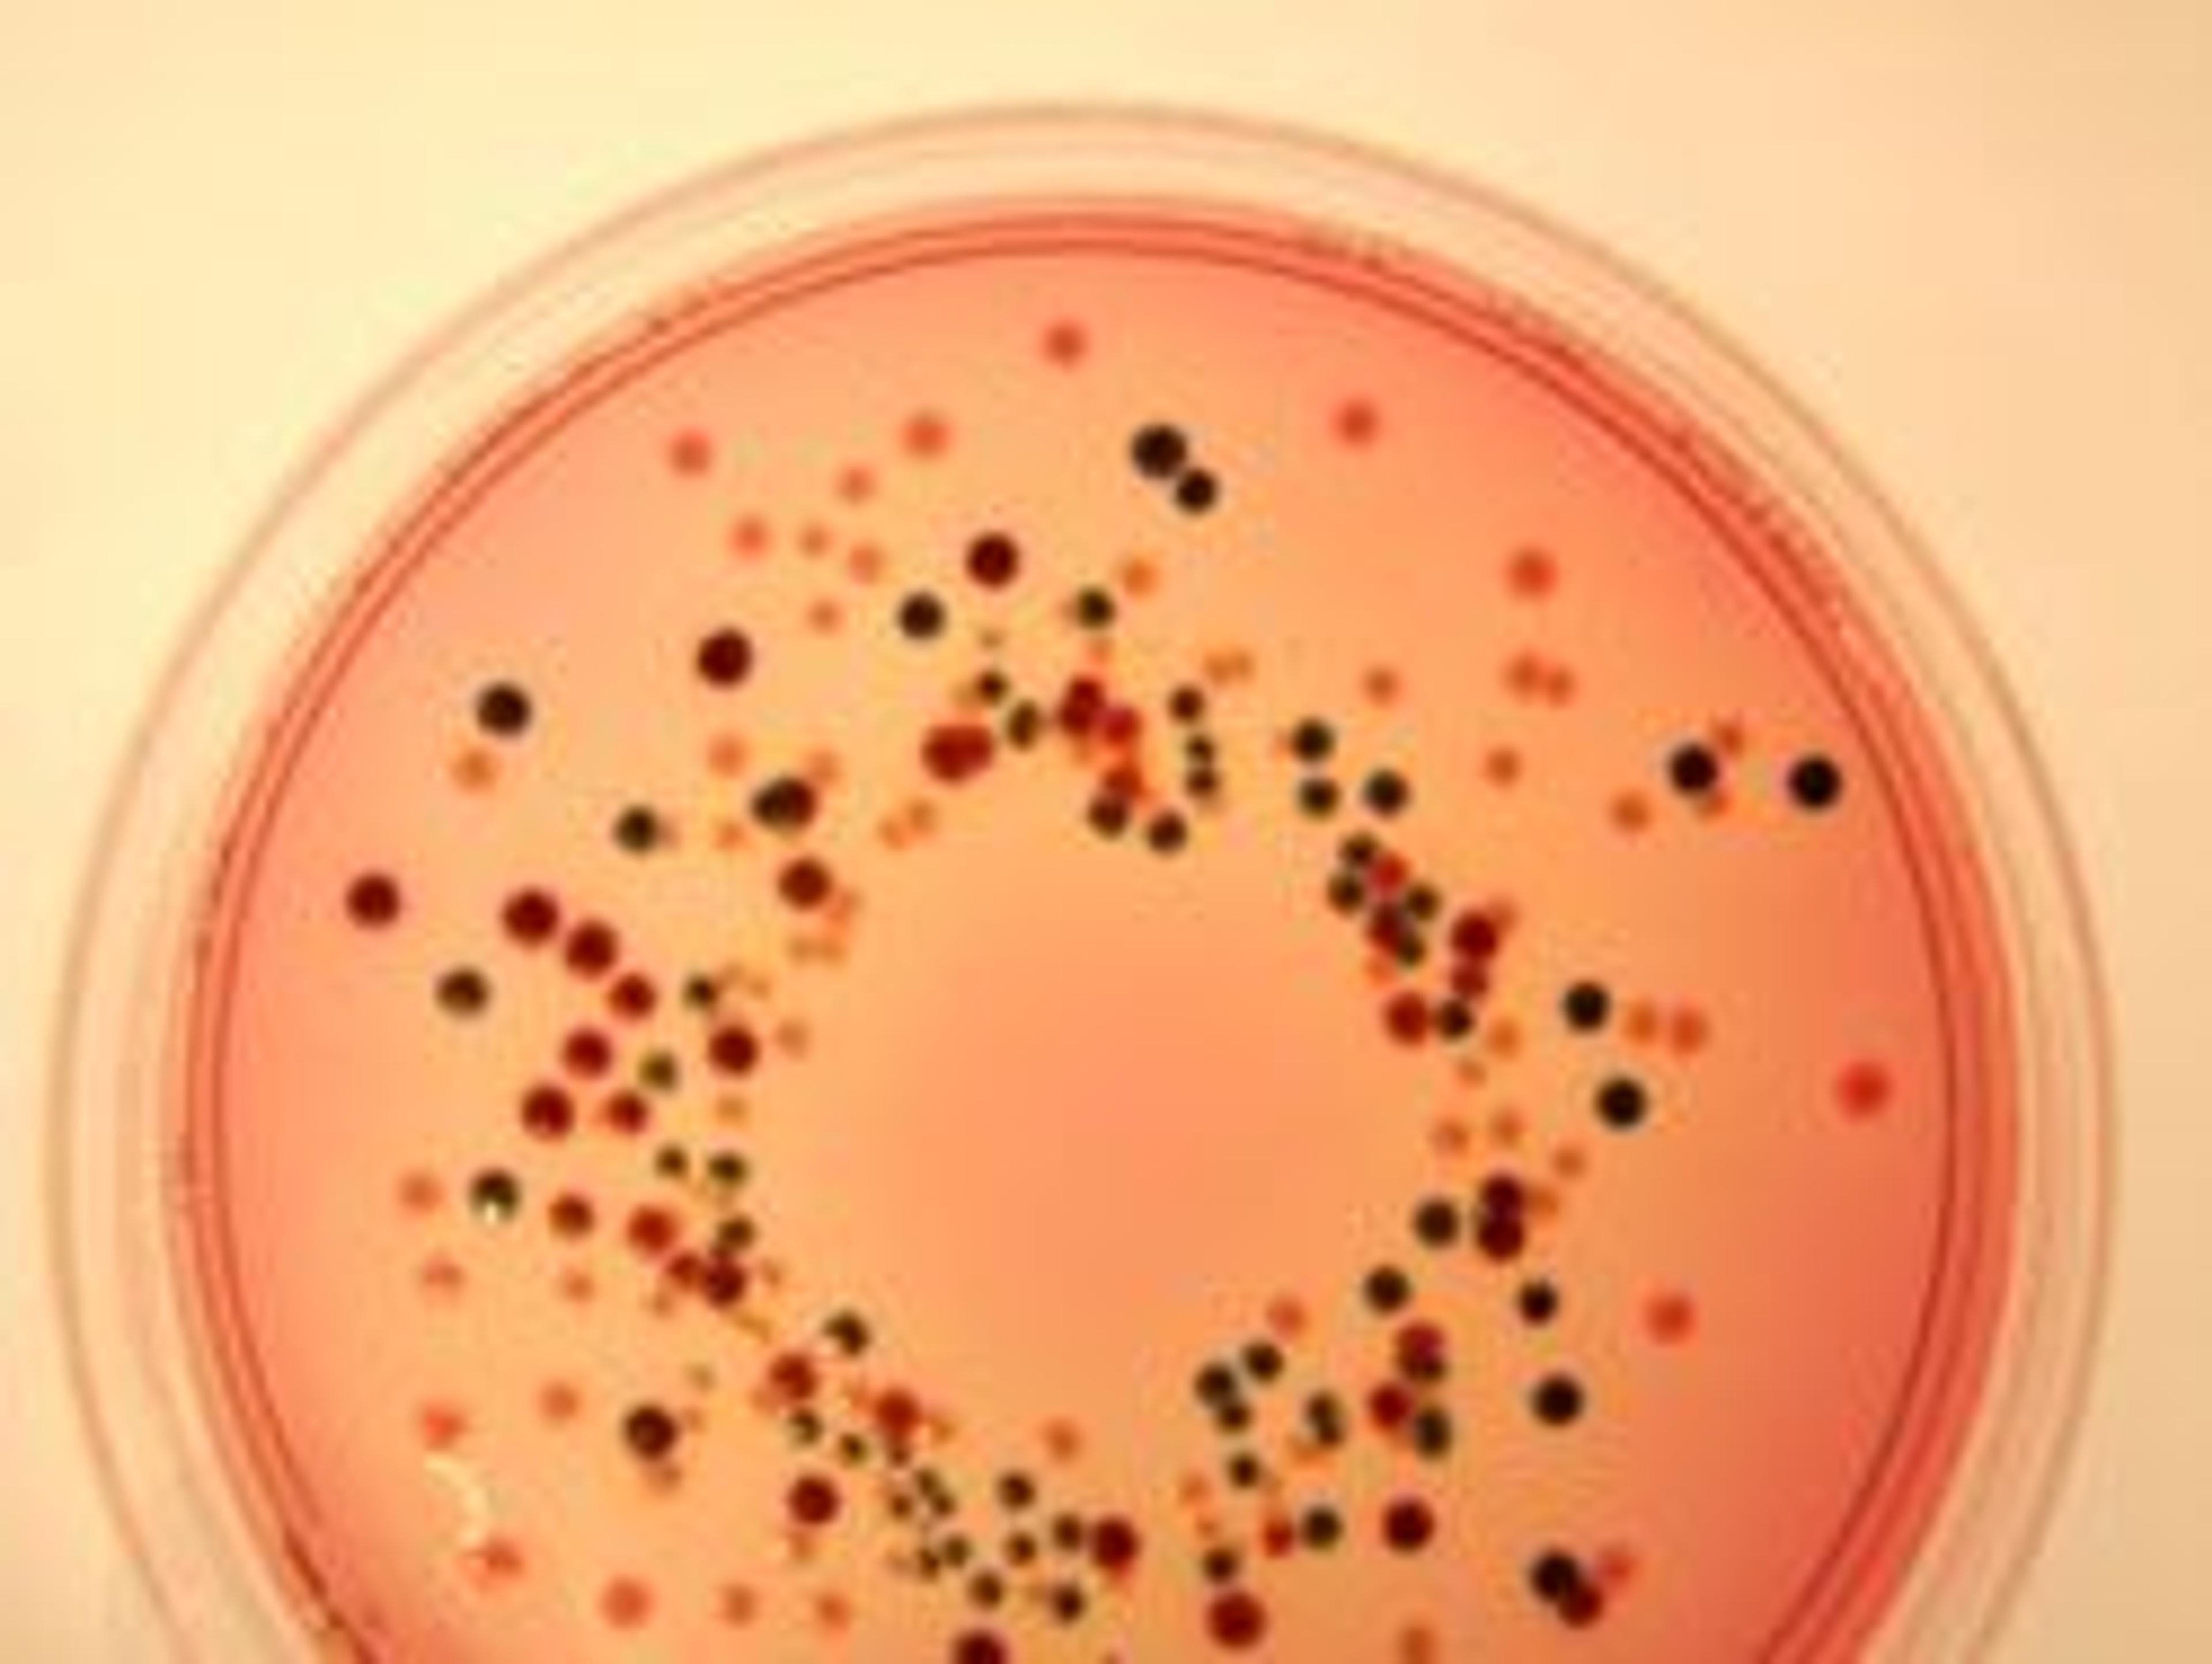
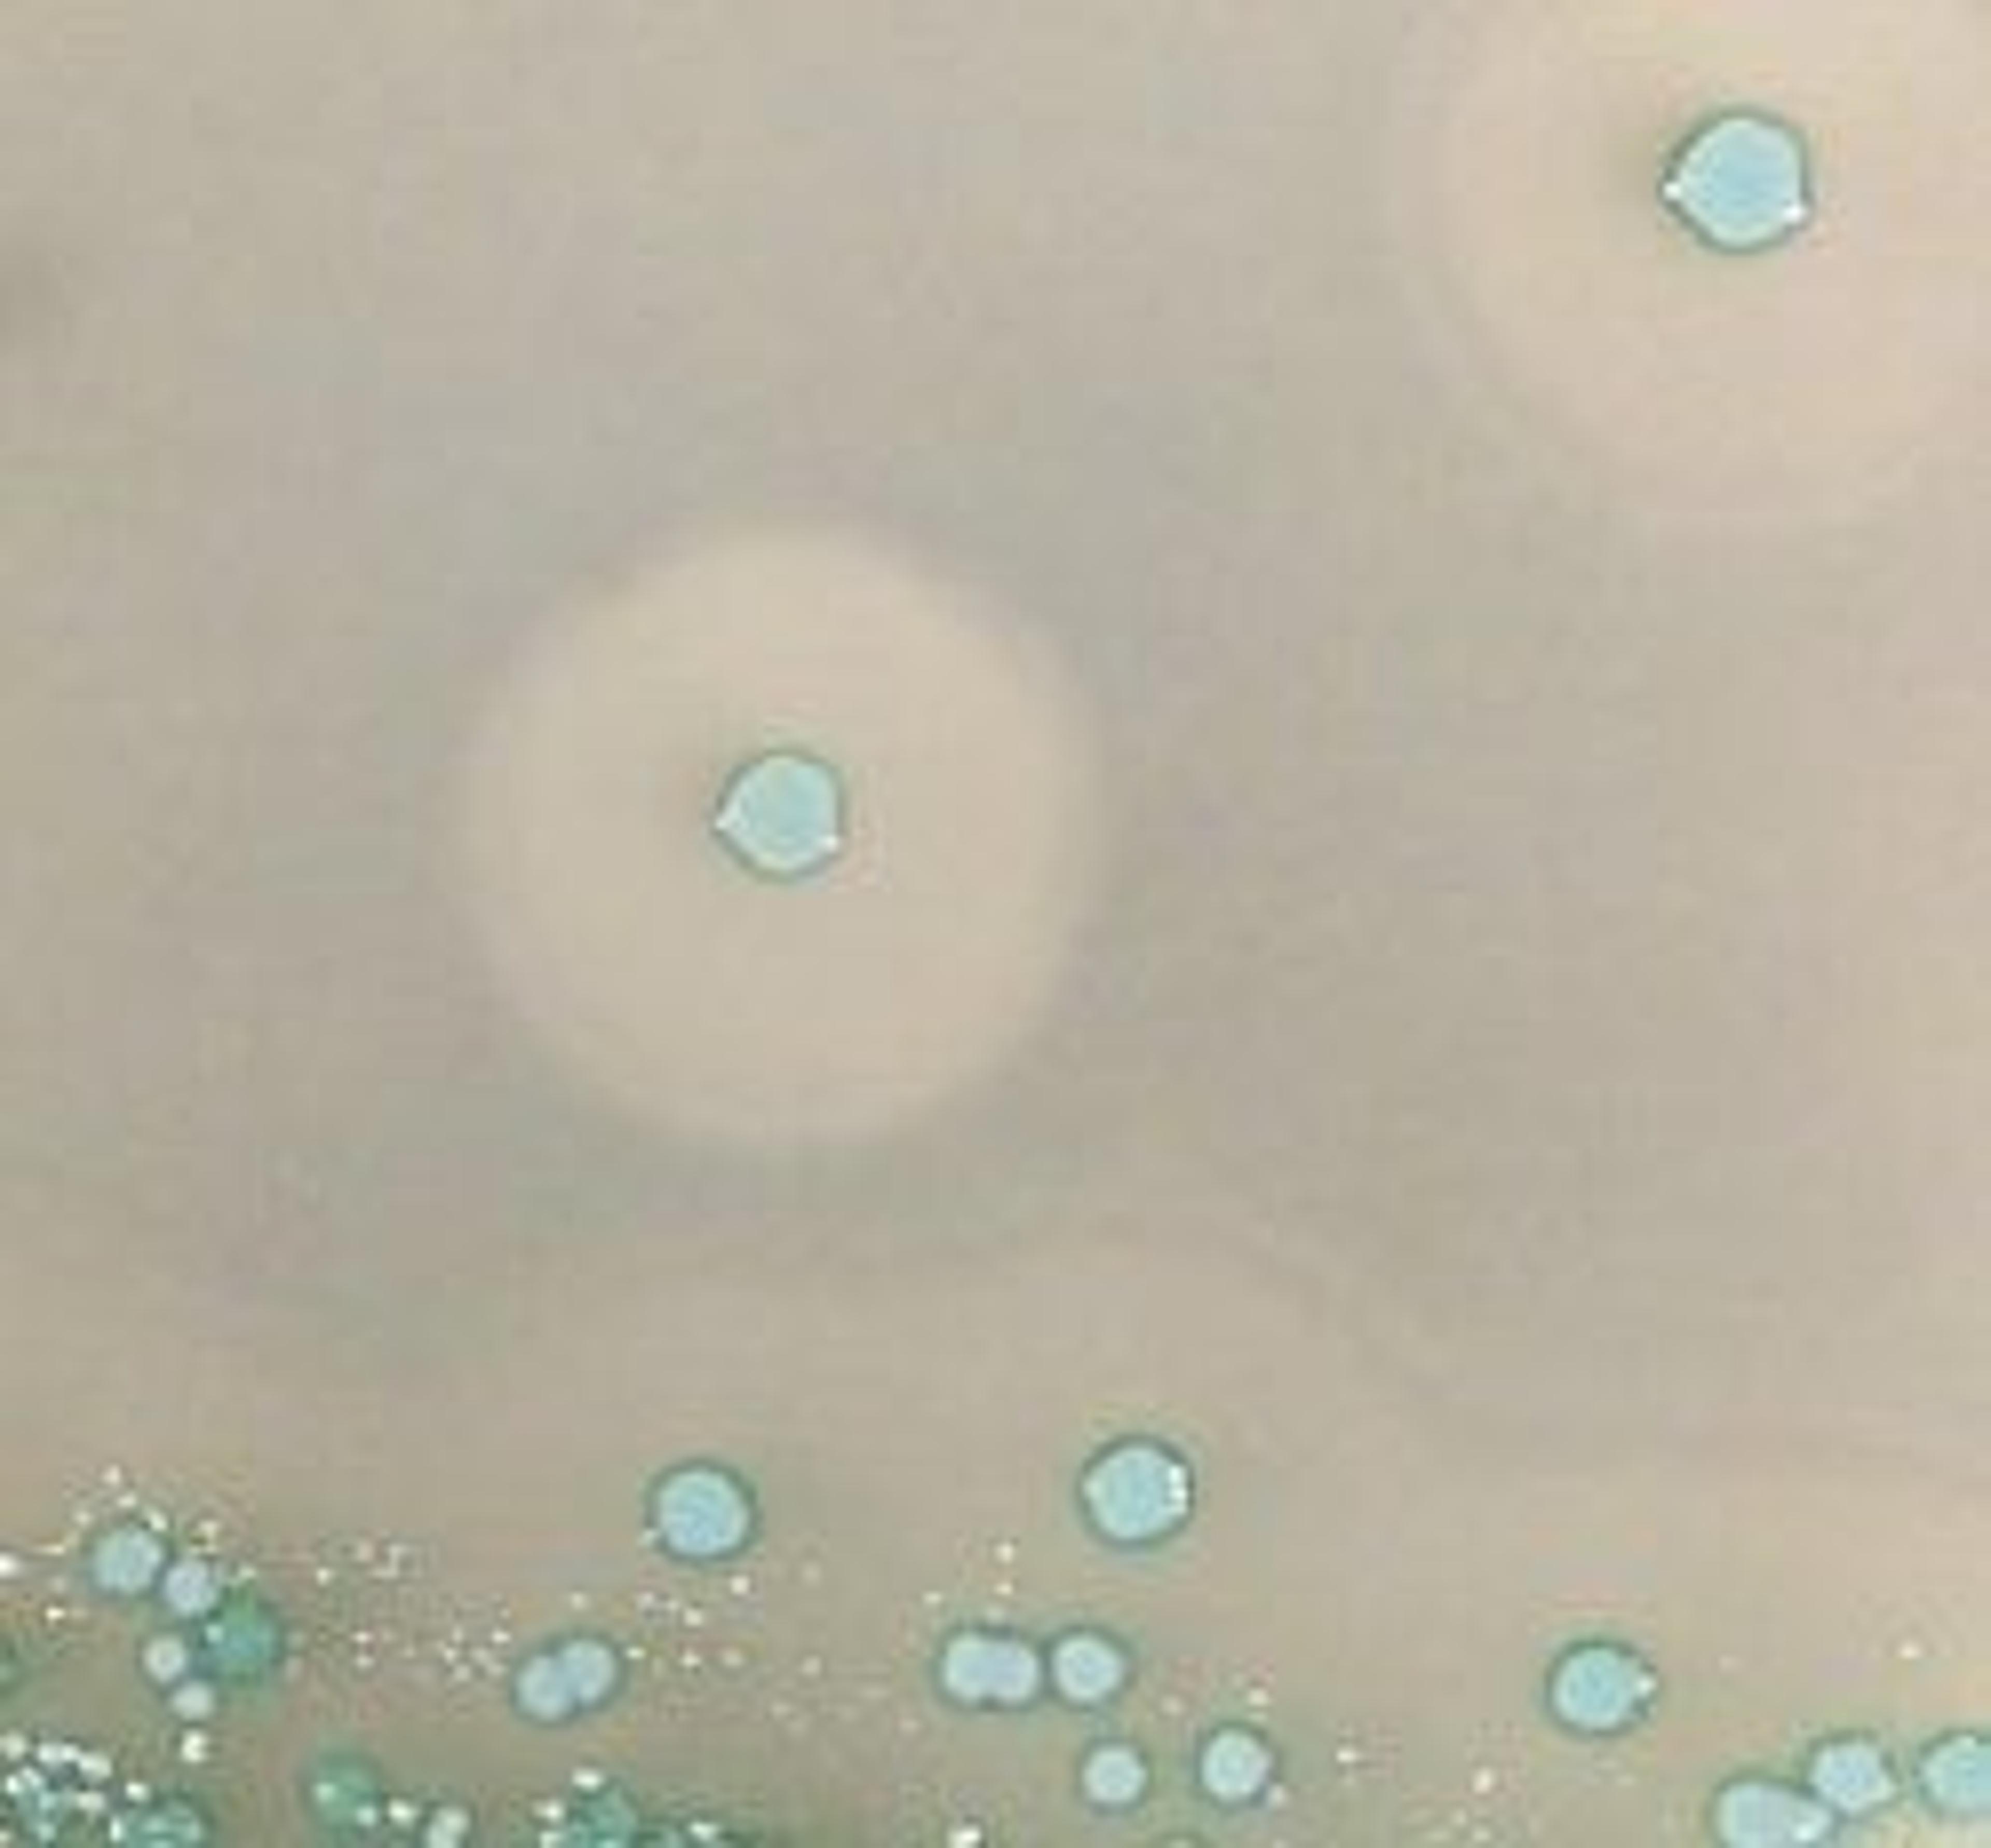
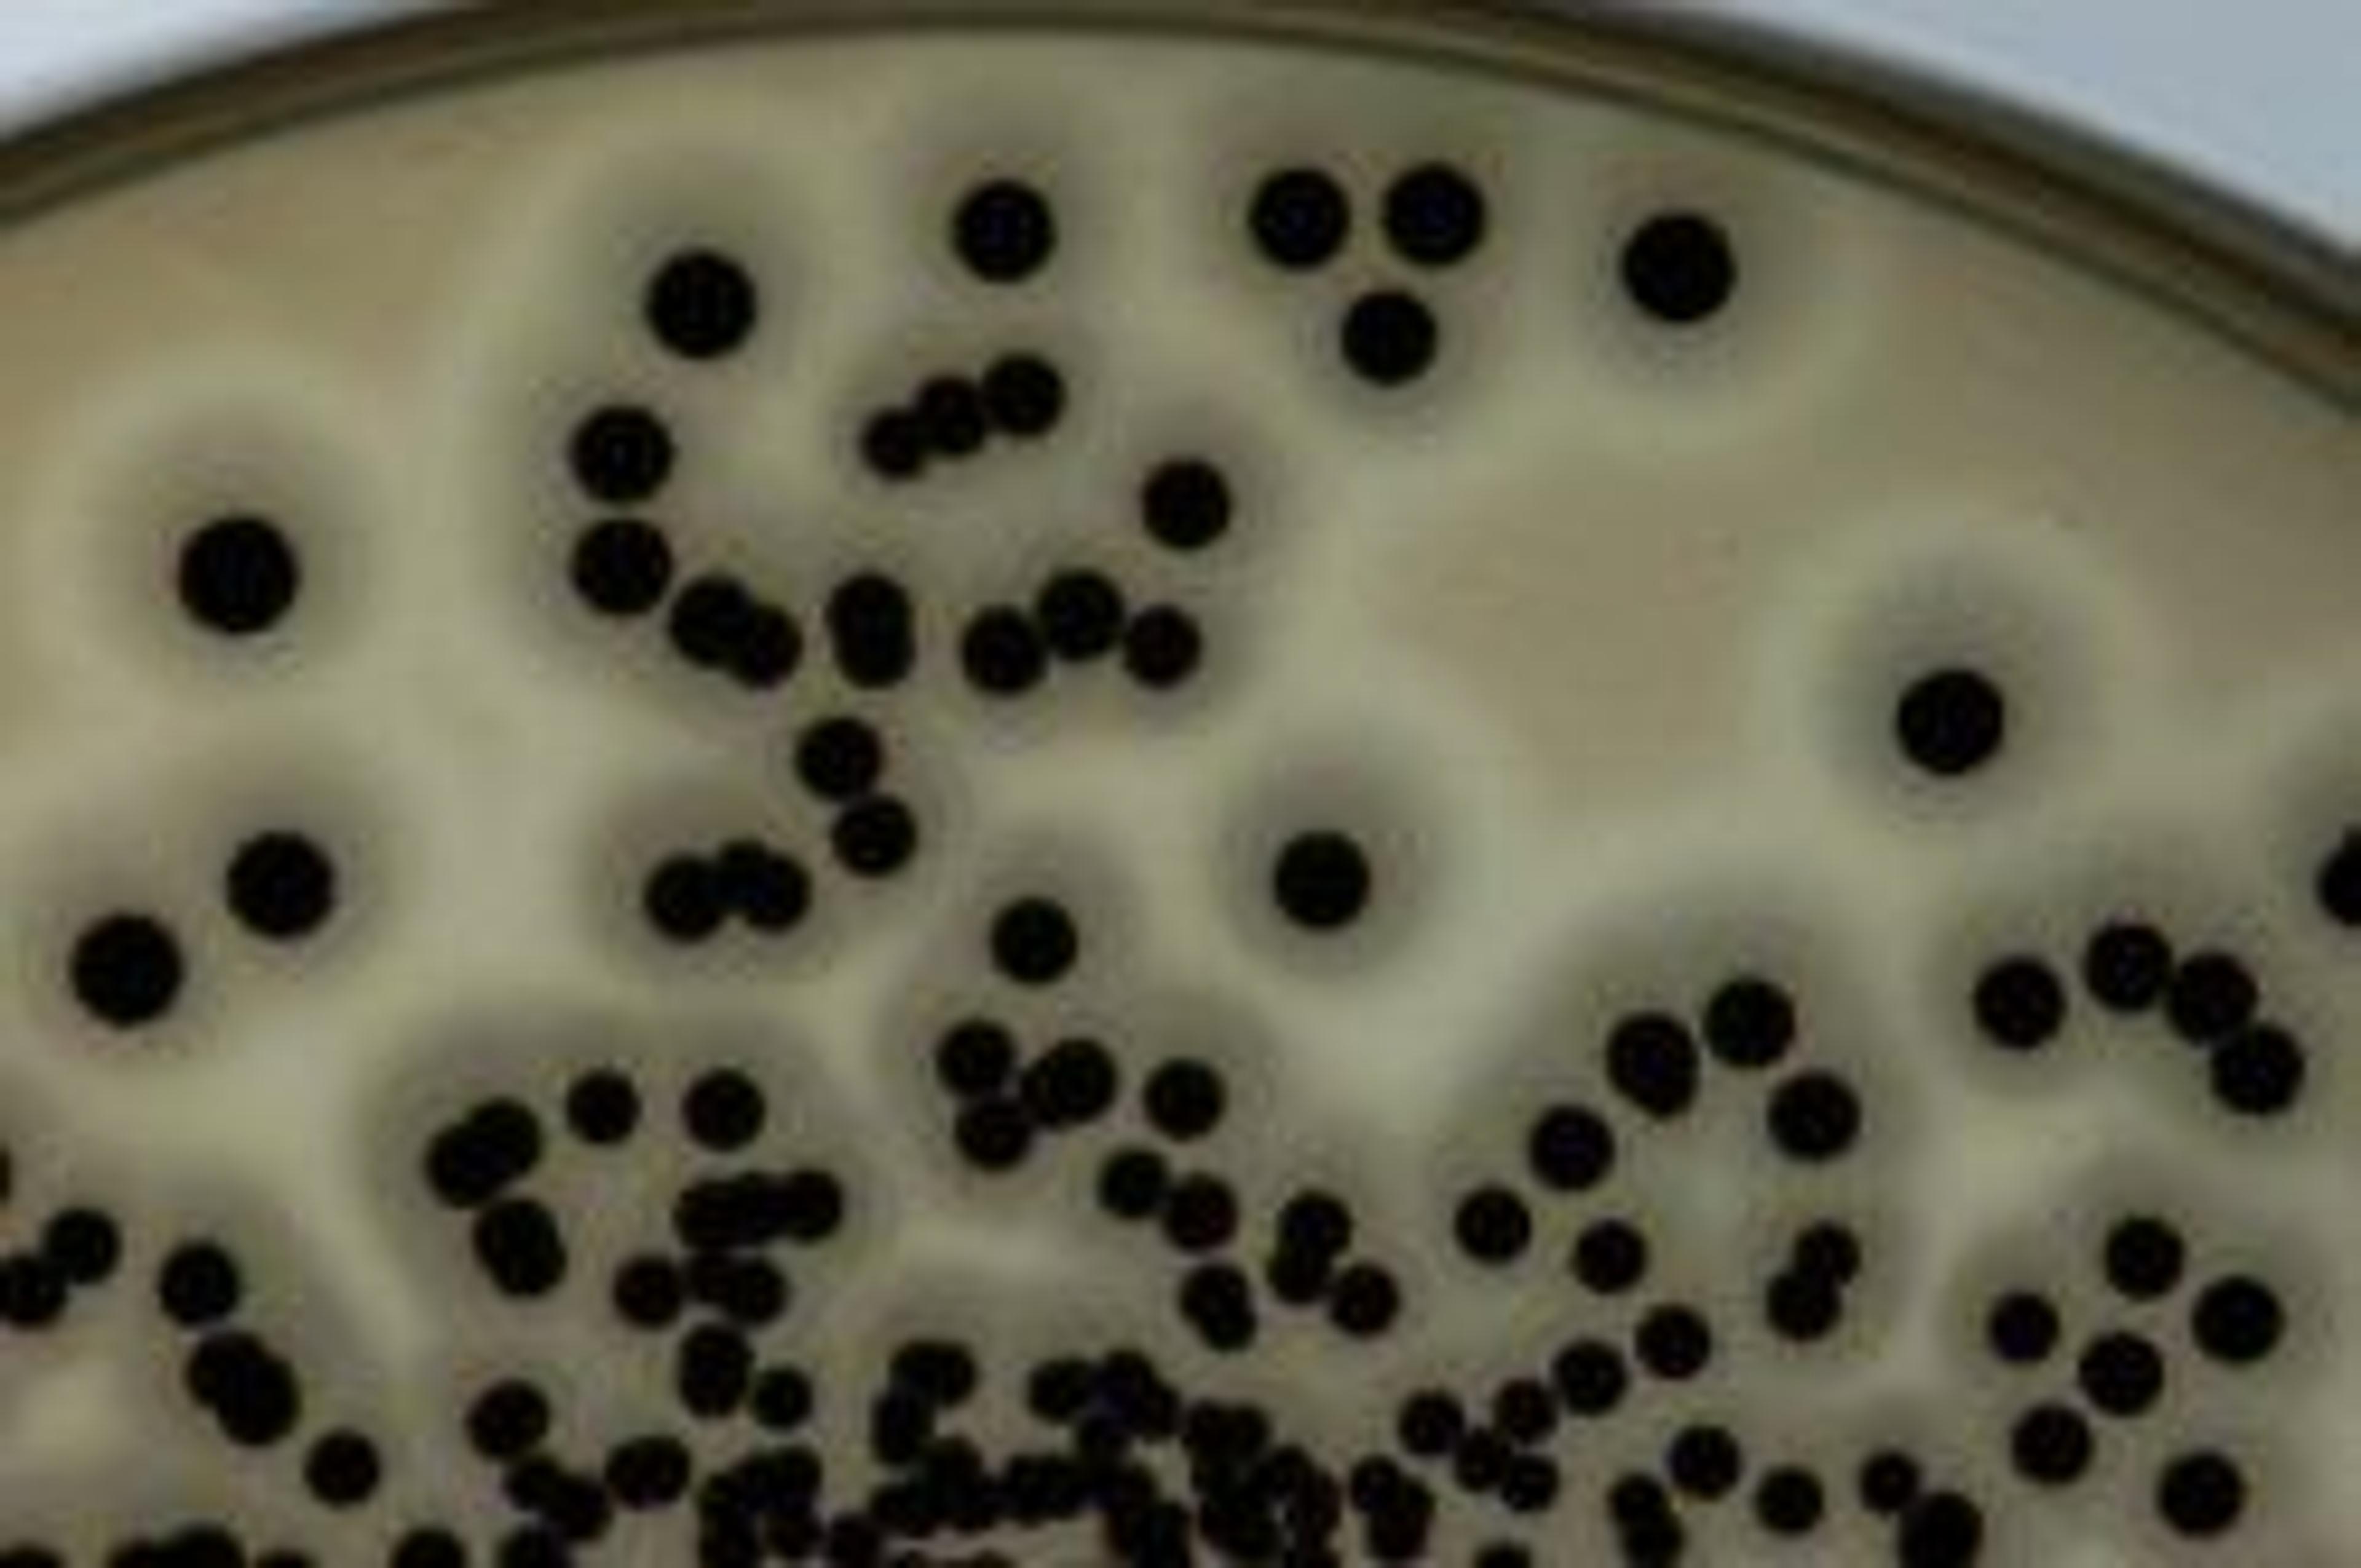
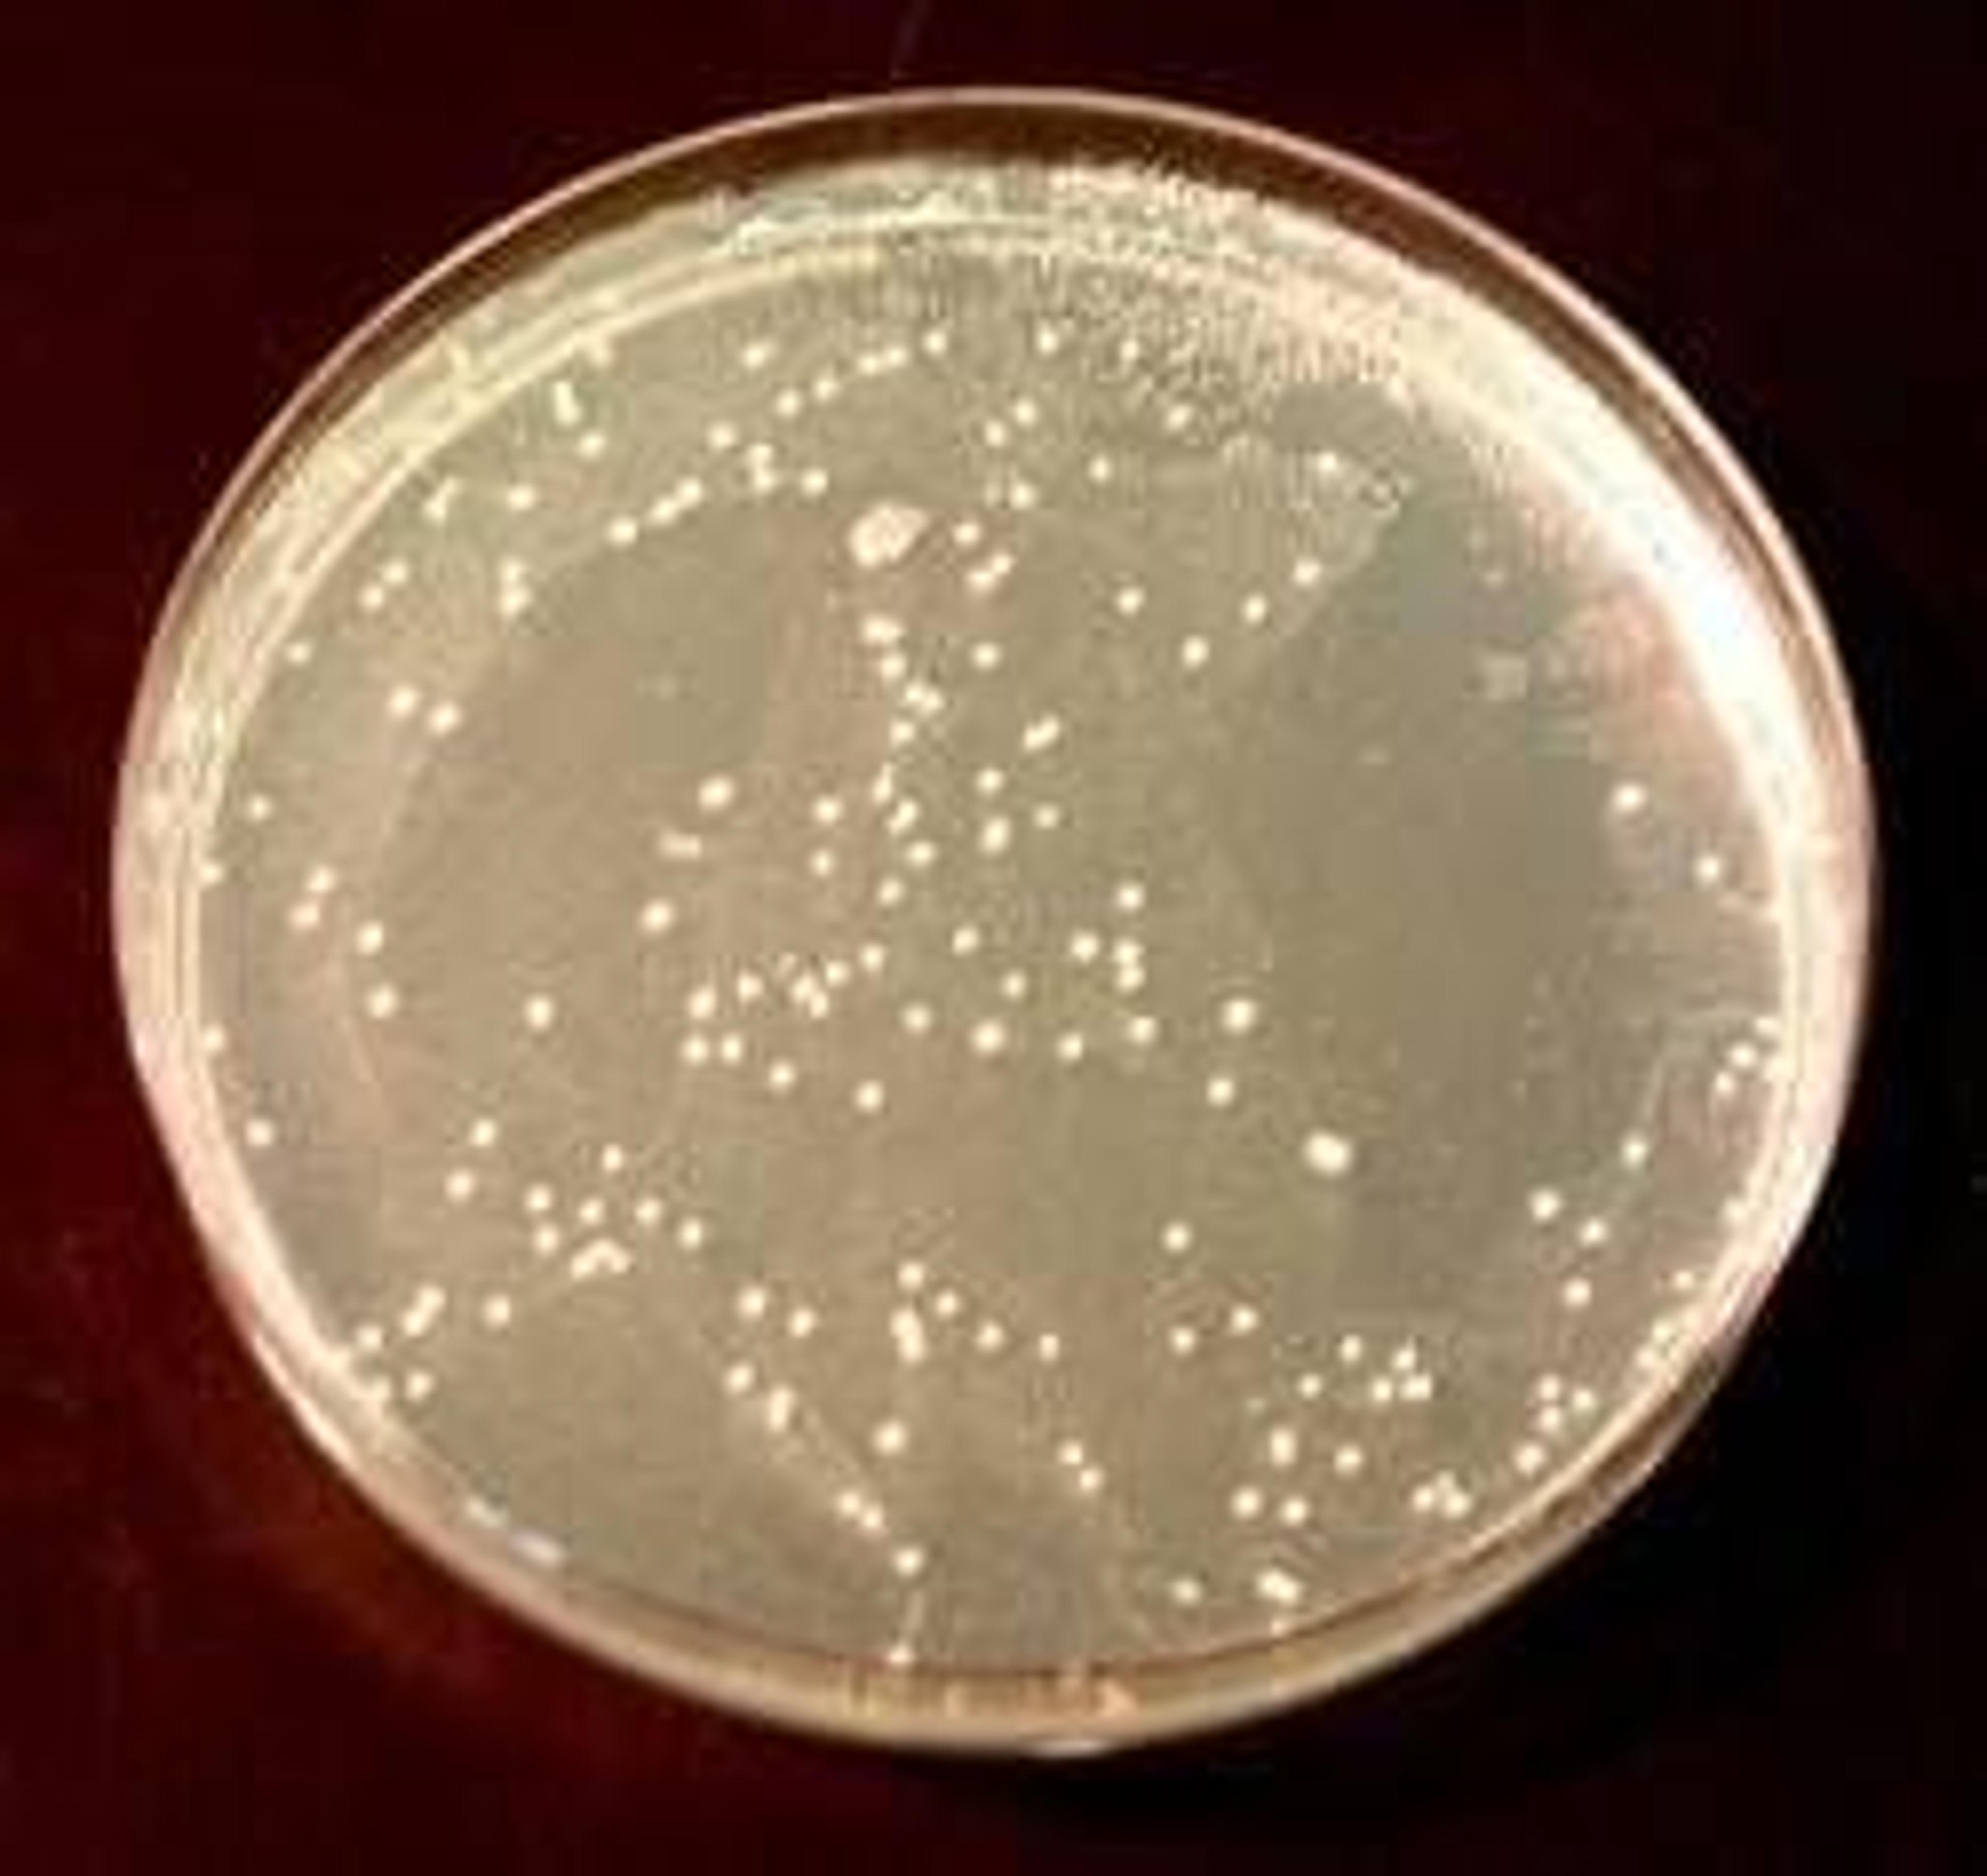

News & Articles
25
Selected Filters:
Product News
Lab M Helping to Tackle Fungal Food Spoilage
Product News
Microbiology in colour!
Product News
Lab M launches new coliform medium for milk
Product News
Lab M launches ISO Nutrient Agar
Product News
Lab M showcases wide range of DCM at Medica 2007
Product News
Lab M launches ISO compliant Baird-Parker medium
Product News
Lysine Agar heads Lab M’s brewing range
Product News